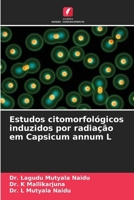
Estudos citomorfológicos induzidos por radiação em Capsicum annum L (Portuguese Edition) 6208337615 Book Cover

Most Popular Books
- Studi citomorfologici indotti dalle radiazioni in Capsicum annum L (Italian Edition)
- Études cytomorphologiques induites par les radiations chez Capsicum annum L (French Edition)
- Estudos citomorfológicos induzidos por radiação em Capsicum annum L (Portuguese Edition)
- Strahleninduzierte zytomorphologische Studien an Capsicum annum L (German Edition)